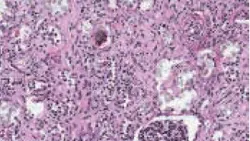

A Guide to Ethylene Glycol Toxicosis in Dogs & Cats
Jill A. Richardson, DVM, ASPCA Animal Poison Control Center
Sharon M. Gwaltney-Brant, DVM, PhD, ASPCA Animal Poison Control Center
Definition
Poisoning with agents containing ethylene glycol (EG) (antifreeze; aircraft de-icer;solvents; hydraulic brake fluids; windshield washer fluids; agents in condensers, heat exchangers, and home solar units).1,2 EG is also used in portable basketball goal post bases and toilets of recreational vehicles/ homes in colder climes.

Calcium oxalate crystals, shown above, can be produced as ethylene glycol is metabolized.
Systems
Gastrointestinal tract, CNS, cardiopulmonary, and renal. Vomiting usually within the first few hours; CNS depression, ataxia, weakness, tachypnea, polyuria/polydipsia occur within 1 to 6 hours. By 18 to 36 hours, acute renal failure develops.3,5
Relative Species Sensitivity
Most Sensitive: cat, rabbit, human
Moderately Sensitive: dog, cattle, pig, rodent
Least Sensitive: fish, poultry
Toxic Doses
Toxic dose has not been established. Lethal dose of undiluted antifreeze (95-97%) by volume is 4.4 to 6.6 ml/kg (dogs) and 1.4 ml/kg (cats).2,5 Most acute toxicity data based on doses causing early death (acidosis/intoxication) do not account for animals surviving initial stages that later succumb to kidney failure. Thus, any suspected exposure should be considered potential toxicosis, with steps to determine extent. When in doubt, treat as toxic.
History
Exposure/possible exposure
Roaming or unsupervised animal
Evidence of exposure (radiator leaks, chewed container)
Vomiting, lethargy, ataxia
Fluorescence under Wood's lamp of urine, stomach contents, paws/muzzle
Physical Examination
Clinical signs categorized into 3 stages: neurologic (initial inebriation from alcohol), cardiopulmonary (severe acidosis/electrolyte disturbances), renal (direct injury from toxic metabolites created by breakdown of EG and from tubular injury from calcium oxalate crystals).1-4,6 However, may be asymptomatic; clinical signs often change during course; and stages can overlap, be skipped, or go unobserved. Death can occur at any stage.
Stage 1: Neurologic
Typically begins ≤ 30 minutes, lasting to 12 hours.1-4,6 Vomiting common, most likely because EG irritates gastric mucosa.2,3 Initial ataxia, disorientation, stupor, polyuria/polydipsia.3,4,6 These are early indicators of possible poisoning, important because early intervention is more likely to save an animal. Coma and death possible, or animal may appear to partially/fully recover. By 6 to 12 hours,neurologic status may worsen due to severe metabolic acidosis.3,4,6 Isosthenuria in dogs by 3 hours from osmotic diuresis/serum hyperosmolality-induced polydipsia.2,3
Stage 2: Cardiopulmonary
Generally from 12 to 24 hours. Tachypnea, tachycardia, CNS depression, seizures, pulmonary edema may occur.1-4,6 High anion gap and severe metabolic acidosis typical.3,4,6 Most deaths in humans reported at this stage.1
Stage 3: Oliguric renal failure
As early as 12 hours, especially in cats, but generally within 24 to 72 hours.2,3,5,6 Azotemia, depression, anorexia, vomiting, abdominal pain, and oliguria progressing to anuria.1,3 Low urine specific gravity and glucosuria with calcium oxalate crystals possible.3,4 Clinical pathologic abnormalities include increased osmolar gap/anion gap, hyperglycemia, hyperkalemia, decreased blood pH, hypocalcemia.1,3 BUN and creatinine generally do not increase until ≥ 12 hours after exposure; thus, testing has little benefit.
Kinetics & Metabolism
EG is rapidly absorbed, although food in stomach may slow absorption.1,3 Clinical signs may occur as early as 30 minutes; peak blood concentrations in dogs 1 to 4 hours after ingestion.6 Plasma half-life is 3 to 5 hours; therapeutic ethanol or fomepizole may increase half-time to 12 to 72 hours.1,3 Primarily eliminated through kidneys; about 50% excreted unchanged.3,4
Metabolism occurs primarily in liver, forming toxic acidic metabolites (see EG Metabolism).1,2,5,6 Oxalic acid is directly cytotoxic to the renal tubular epithelium and induces hypocalcemia by binding to serum calcium to form calcium oxalate crystals.1-3,6 Crystals precipitate in renal tubules, causing mechanical injury and possibly obstructive uropathy.2
EG Metabolism
EG oxidation to glycoaldehyde via alcohol dehydrogenase.
Glycoaldehyde oxidation to glycolic acid via mitochondrial aldehyde dehydrogenase.
Glycolic acid oxidation to glyoxylic acid, the most toxic metabolite. Short half-life of glycoxylic acid prevents accumlation of toxic concentrations.1
Glyoxylic acid oxidation through several pathways to produce oxalic acid, glycine, formic acid, hippurate, benzoic acid, and other compounds.
Oxalic acid binds to serum calcium and forms calcium oxalate crystals.
Differentials
Diagnostic differentials for EG toxicity can be found in standard reference texts.
Causes of Increased Anion Gap
Decreasing unmeasured cations (hypocalcemia, hypomagnesemia, hypokalemia)7
Increasing unmeasured anions (ketoacids, lactate, phosphates, sulfates, salicylates, methanol, albumin)7
Most common cause (dogs and cats) is metabolic acidosis due to lactic acidosis, renal failure, or ketoacidosis7
Ruleouts for Acute Renal Failure
Acute decompensation of chronic renal failure
Cholecalciferol/vitamin D3 derivatives, hypervitaminosis D, hypercalcemia
Glomerulonephritis
Grapes or raisins
Heavy metal intoxication (lead, mercury, cadmium, arsenic, zinc)
Heatstroke
Hemoglobinuria, myoglobinuria
Hypoadrenocorticism
Hypovolemia
Leptospirosis
Nephrotoxic antibiotics
NSAID overdose
Oxalic acid ingestion
Plant ingestion (Lilium species, Hemerocallis species [in cats only], rhubarb leaves, and Oxalis species)
Septic shock
Crotalid snake bite
Urinary obstruction
Ruleouts for Metabolic Acidosis
Acute renal failure
Aspirin or NSAID overdose
Diabetes mellitus
Ethanol, methanol, other short-chain alcohols
Metaldehyde toxicosis
Blood & Urine Analysis
Early Diagnosis/Treatment Essential
Diagnosis based on history, clinical signs, laboratory testing. Peak EG levels reached ≤ 1 to 4 hours, but tests can be done from 0.5 to 12 hours.3 One kit is available for veterinary use (EGT Kit-PRN Pharmacal). Labeled for dogs with levels > 50 mg/dl, this kit can be invaluable in determining if treatment is warranted.3,4 False-positive results can occur (presence of propylene glycol in some activated charcoal solutions and injection solutions such as pentobarbital and diazepam, other glycols, or formaldehyde in the circulation).3,4,6 Blood should be taken before administering any such solutions/ agents. Products causing false positives are metaldehyde, glycerin/glycerol, or diethylene glycol. Other alcohols (e.g., ethanol, methanol, or isopropanol) do not interfere.3
Cats are more sensitive to EG than dogs, and kit may not diagnose toxicosis. Positive results are significant, but negative results do not rule out toxicosis. Some human laboratories run quantitative EG analysis. Any detectable EG warrants treatment.
Other Diagnostic Procedures
Measure anion gap (>25 mEq/L) or serum osmolality (> 20 mOsm/kg).2-4,6
Crystalluria (not conclusive)2
Calcium oxalate crystals in urine can be seen 6 hours after ingestion; may be octahedral (envelope-like), prismatic (spindles, hippurate-like), or dumbbell shaped.1
Examine urine under Wood's lamp; will show fluorescein dye up to 6 hours.3
Diagnosing Toxicosis
Increased osmolar gap (>20 mOsm/kg)
Decreased blood pH
Increased anionic gap (>25mEq/L)
Toxin in serum or urine
Hypocalcemia
Early-phase ataxia (1-3 hours)
Calcium oxalate crystalluria
Fluorescence of urine or vomitus on Wood's lamp
Postmortem Findings
Renal: Proximal tubular degeneration/ necrosis, calcium oxalate deposition; calcium oxalate crystals in intestinal mucosa, liver, heart, brain3,4
CNS: Cerebral edema, multifocal hemorrhage, inflammatory cell infiltration3,4
Treatment
Must be timely and aggressive. Failure to initiate in first several hours may result in irreversible renal damage/death. Goals are to stabilize, prevent absorption, interfere with toxin metabolism, provide supportive care.
Induction of emesis helpful only < 1 hour. Feeding dry bread before emesis may increase success. Emesis contraindicated with hyperactivity, tremor, seizures: consider gastric lavage.8 Effective emetic is 1 teaspoon 3% hydrogen peroxide per 5 lb, not to exceed 3 tablespoons.8 Usually occurs in minutes; dose can be repeated once if initially unsuccessful. Another option is apomorphine hydrochloride, administered topically to eye or parenterally at 0.03 mg/kg IV or 0.04 mg/kg IM in dogs; 0.04 mg/kg IV or 0.08 mg IM or SC in cats.8 CNS/respiratory depression, ataxia, excitement, protracted vomiting can occur, especially after IV administration.8
Activated charcoal can be given (1-3 g/kg, 1-3 hours after ingestion). Effectiveness is controversial-aliphatic alcohols may not be well adsorbed by charcoal.1,3 Take samples for EG analysis before activated charcoal to prevent false positives resulting from detection of glycols in these compounds.
Altering Kinetics
IV fomepizole and ethanol have been successful. Compounds aim to delay/prevent breakdown of toxin to more toxic metabolites, allowing excretion of unchanged parent compound in urine.
Fomepizole inhibits alcohol dehydrogenase; considered preferred treatment for dogs3,4,16 but may not be effective in cats.3,5,9,10 Unlike ethanol, does not cause hyperosmolality, metabolic acidosis, CNS depression 3,9,11,16
Administer every 12 hours for 36 hours. Dosing is 20 mg/kg slow IV over 15 to 30 minutes, then 15 mg/kg slow IV at 12 and 24 hours, then 5 mg/kg at 36 hours.3,9,10
Ethanol competes with EG as substrate for alcohol dehydrogenase; can be used in dogs and cats.3,4,6,10 Inexpensive and readily available; has serious drawbacks (worsening of metabolic acidosis and CNS depression), making evaluation of degree of toxicosis difficult.11,13 Ethanol treatments are time-intensive and require constant monitoring. Ideally, administer 8.6 ml/kg 7% ethanol solution bolus, maintain at 100 mg/kg/hr up to 200 mg/kg/hr constant-rate infusion.10 Or, make a 20% ethanol solution (dogs: 5.5 ml/kg IV every 4 hours for 5 treatments, then every 6 hours for 4 treatments; cats: 5.0 ml/kg IV every 6 hours for 5 treatments, then every 8 hours for 4 treatments.)4,5,10
For dogs, a negative EG test means treatment with fomepizole or ethanol may be discontinued; however, fluid therapy and supportive care should continue until animal fully recovers.
Supportive Care
Preventing further kidney damage/maintaining fluid, electrolyte, acid- base balance are crucial. Fluid therapy is foundation of acute renal failure treatment, comprising fluid diuresis with isotonic alkalinizing crystalloid solution (e.g. lactated Ringer's) twice maintenance rate.10,12 Goals are to correct fluid and electrolyte imbalances, improve renal blood flow, initiate diuresis. Monitor patient to avoid volume overload and possible pulmonary edema. Oliguria necessitates attempts to increase urine output (furosemide, 1 mg/kg/hr for 4 hours then 3 to 8 µg/kg/min to maintain urine flow).10 Dopamine may increase urine output (dogs); administer at 2 to 3 µg/kg/ min.11 Consider peritoneal dialysis in oliguric/anuric animals. Sodium bicarbonate can be used for acidosis (i.e., blood pH <7.10 to 7.15 or total CO2 < 10-12 mEq/L).3,5,10,11 Continue treatment until animal is clinically normal, with at least 24 hours' normal renal function, acid-base parameters.
Precautions
Overhydration: Electrolyte imbalances, volume overload, possibly pulmonary edema
Overuse of sodium bicarbonate: Ionized calcium deficits, CSF acidosis, cerebral edema
Ethanol: Worsening of metabolic acidosis, CNS depression
Alternative Therapy
High doses of fomepizole may be safe and effective in cats if therapy is initiated < 3 hours after ingestion; > 4 hours, mortality rate is 100%.17 Initiating alcohol therapy at home in cases of time delay in obtaining veterinary help has been reported.10 In these cases, 2.25 ml/kg PO 40% alcohol (e.g., vodka, rum) can be administered orally.10
Hemodialysis considered superior to peritoneal dialysis in eliminating EG/metabolites in humans but limited availability in veterinary medicine.1 Pyridoxine and thiamine-cofactors for EG metabolism-recommended in human literature adjunctively.2,4
Relative Cost of Treatment*
Uncomplicated (mild or no clinical signs, no evidence of renal injury): $$-$$
Includes physical examination, decontamination, EG test; baseline clinical laboratory values, ethanol or fomepizole therapy (comparable cost, $-$$, with added nursing/ acid-base monitoring and correction and hospitalization for ethanol treatment), additional serum chemistry values through treatment, and final EG test.
Complicated (severe clinical signs, acidosis +/- renal injury): $$-$$$
Includes physical examination, EG test, correction of emergent signs (e.g. seizures, acidosis), IV fluid administration, baseline clinical laboratory values, ethanol or fomepizole therapy (comparable cost, $-$$ with added nursing/acid-base monitoring and correction with ethanol treatment), additional serum chemistry values through treatment, hospitalization, treatment of acute renal failure ($-$$$), and final EG test.
Cost Key
$ = <$100
$$ = $100-$250
$$$ = $250-$500
$$$$ = $500-$1,000
$$$$$ = >$1,000
(Actual costs will have regional variations)
Patient Monitoring
BUN
Acid-base balance
Creatinine
Urine specific gravity
Calcium
Urine production
Prognosis & Course
Depends on degree of exposure, time before treatment, aggressiveness of treatment. Good if therapy starts < 8 hours and no azotemia.4 Feline mortality rates may be as high as 97%; canine rates, 59% to 70%.3,4 Oliguria/anuria indicates grave prognosis. Animals may fully recover or have residual renal insufficiency requiring lifetime maintenance.
Advice for Owners
The veterinary community can help spread the word about antifreeze safety. Motorists can help prevent accidental EG ingestion. Among considerations are using antifreeze that contains propylene glycol, which is less toxic than EG.
Future Considerations
Researchers at Colorado State University are investigating use of fomepizole in EG-exposed cats.
Treatment At A Glance
Time of Exposure
<1 hour: Induce emesis
1-3 hours: 1-3 g/kg activated charcoal
Then
Dogs: fomepizole-20 mg/kg slow IV over 15-30 mins every 12 hrs for 36 hrs; then 15 mg/kg slow IV at 12 and 24 hrs; then 5 mg/kg at 36 hrs. Tx of choice
OR
Cats or dogs: ethanol-8.6 ml/kg 7% ethanol solution bolus, maintain at 100 mg/kg/hr up to 200 mg/kg/hr constant-rate infusion
OR
20% ethanol solution (homemade)
Dogs: 5.5 ml/kg IV every 4 hrs, 5X; then every 6 hrs, 4X
Cats: 5.0 ml/kg IV every 6 hrs, 5X; then every 8 hrs, 4X
PLUS
Fluid therapy (diuresis with isotonic alkalinizing crystalloid, e.g., lactated Ringer's), twice maintenance rate
Editor's note: This article was originally published in January 2003 as "Ethylene Glycol Toxicosis in Dogs & Cats"